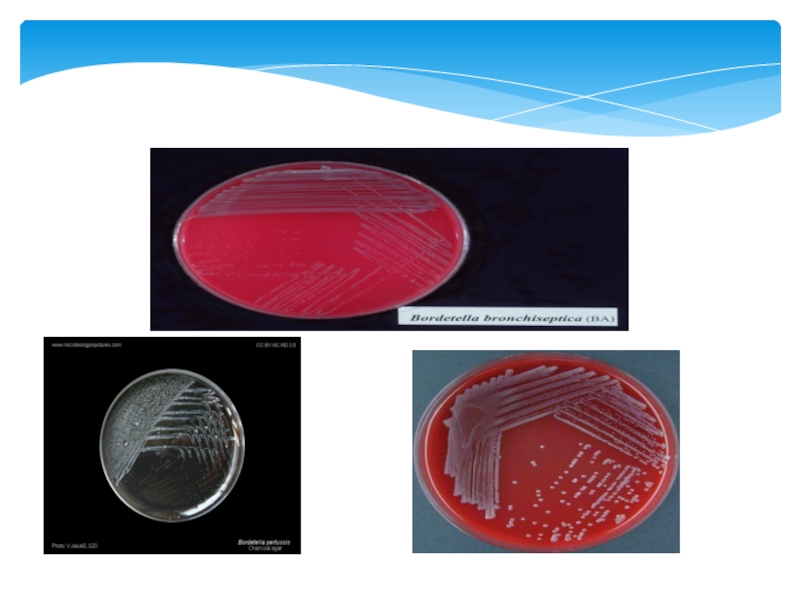

Разделы презентаций
- Разное
- Английский язык
- Астрономия
- Алгебра
- Биология
- География
- Геометрия
- Детские презентации
- Информатика
- История
- Литература
- Математика
- Медицина
- Менеджмент
- Музыка
- МХК
- Немецкий язык
- ОБЖ
- Обществознание
- Окружающий мир
- Педагогика
- Русский язык
- Технология
- Физика
- Философия
- Химия
- Шаблоны, картинки для презентаций
- Экология
- Экономика
- Юриспруденция
Бордетеллы
Содержание
- 1. Бордетеллы
- 2. Бордетеллы (лат. Bordetella) — род бактерий, объединяющий мелкие грамотрицательные
- 3. Впервые бордетеллы выделены в 1906 г. французскими микробиологами Ж. Борде и О. Жангу.
- 4. Слайд 4
- 5. Очень мелкие овоидной формы, грамотрицательные палочки (коккобактерии).
- 6. Слайд 6
- 7. Слайд 7
- 8. Слайд 8
- 9. Слайд 9
- 10. Слайд 10
- 11. Слайд 11
- 12. Патогенез и характеристика заболеванияВ. pertussis вызывает коклюш –
- 13. Выделяют 3 периода заболевания. Начальный катаральный период
- 14. Слайд 14
- 15. Лабораторная диагностикаКлинический диагноз может быть установлен при
- 16. Слайд 16
- 17. Слайд 17
- 18. СПАСИБО ЗА ВНИМАНИЕ!
- 19. Скачать презентанцию
Бордетеллы (лат. Bordetella) — род бактерий, объединяющий мелкие грамотрицательные неподвижные коккобациллы, растущие на среде Борде-Жангу и на казеиново-угольном агаре; аэробы, спор не образуют, биохимически малоактивны; возбудители коклюша и коклюшеподобных заболеваний у человека. Род
Слайды и текст этой презентации
Слайд 1Бордетеллы
Выполнил студент 3-курса 302-группы лечебного факультета
Выполнил: Ватанов Ф
Проверила: Кулагина
К.А
Слайд 2Бордетеллы (лат. Bordetella) — род бактерий, объединяющий мелкие грамотрицательные неподвижные коккобациллы, растущие
на среде Борде-Жангу и на казеиново-угольном агаре; аэробы, спор не
образуют, биохимически малоактивны; возбудители коклюша и коклюшеподобных заболеваний у человека.Род назван в честь бельгийского иммунолога и бактериолога Жюля Борде (1870—1961).
Слайд 4
Классификация
Возбудители относятся к семейству
Alcaligenaceae, роду Bordetella. В настоящее время род включает 9 видов бордетелл. Патологию у человека вызывают 3 вида бактерий: В. pertussis – возбудитель коклюша, В. parapertusis – паракоклюша; В. bronchiseptica является возбудителем болезней животных, у человека весьма редко вызывает респираторные инфекции (оппортунистический патоген). Слайд 5Очень мелкие овоидной формы, грамотрицательные палочки (коккобактерии).
Не имеют спор,
жгутиков (кроме B. bronchiseptica). Возбудители коклюша имеют капсулу. При окраске толуидиновым
синим выявляются метахроматические биполярные гранулы. Морфология
Слайд 6 Культуральные
свойства
Требовательны к питательным средам. Нуждаются в факторах роста. В среды
добавляют аминокислоты (цистеин, метионин), никотиновую кислоту, кровь, а также ионообменные смолы или уголь. Уголь, кровь, ионообменные смолы добавляют в среды для адсорбции жирных кислот, которые образуются в процессе роста бордетелл и подавляют их размножение.
Лучшими средами являются глицерино-картофельно-кровяной агар (среда Борде-Жангу); КУА (казеиново-угольный агар). На этих средах возбудитель коклюша образует колонии в виде капелек ртути, паракоклюша – коричневые колонии.
Время культивирования – 48-72 часа.
При росте возбудители коклюша диссоциируют на 4 типа:
I – вирулентные бордетеллы, S -формы, имеют пили; II и III – RS-формы (переходные); IV – авирулентные R-формы, пили отсутствуют.
Слайд 8 Биохимические свойства
Биохимическая
активность не выражена. Строгие аэробы, каталазоположительны. Белки и углеводы не
разлагают.Слайд 9
Антигенная структура
Имеется 14 вариантов О-антигена клеточной стенки,
для всего рода характерен антиген 7, для возбудителя коклюша дополнительно специфический антиген – 1, для возбудителя паракоклюша – 14, для B. bronchiseptica – 12. Их выявляют в реакции агглютинации с монорецепторными сывороткамиСлайд 10
Факторы патогенности
Синтез и
продукция большинства факторов патогенности находится под контролем генов вирулентности бордетелл (bvgA и bvgS), которые образуют генетический bvg-регулон.Возбудители коклюша обладают набором факторов адгезии, определяющих их тропизм к эпителию верхних дыхательных путей. Ведущим является филаментозный гемагглютинин, который связывается с интегриновыми рецепторами мерцательного эпителия трахеи. Бактерии имеют многочисленные фимбрии.
Слайд 11
Резистентность
Бордетеллы – весьма чувствительные микроорганизмы, быстро погибают под действием солнечных лучей или при повышении температуры. Не проявляют устойчивости к основным антисептикам и дезинфектантам.
Слайд 12Патогенез и характеристика заболевания
В. pertussis вызывает коклюш – острое антропонозное респираторное
инфекционное заболевание, которое характеризуется циклическим течением и приступообразным спастическим кашлем.
В. parapertusis
вызывают паракоклюш – заболевание, сходное по клинике с коклюшной инфекцией, но с более легким течением. Возбудитель коклюша весьма контагиозен. При контакте с источником инфекции вероятность непривитых лиц заболеть превышает 70%. Болеют преимущественно дети.
Источник инфекции – больной ребенок и бактерионоситель. Путь передачи – воздушно-капельный.
Инкубационный период болезни составляет 1-2 недели.
Для заболевания характерны тяжелые приступы пароксизмального кашля, иногда приводящие к рвоте, ларингоспазму и кратковременной асфиксии.
Возбудитель при помощи адгезинов связывается с мерцательным эпителием трахеи и бронхов, быстро размножается на поверхности клеток и выделяет токсины. Он не способен проникать в нижележащие слои.
Слайд 13Выделяют 3 периода заболевания.
Начальный катаральный период очень заразен. Сопровождается
насморком, кашлем, длится около 2-х недель. Для периода судорожного кашля
характерны приступы кашлевых пароксизмов, его длительность составляет 4-6 недель. В конце периода при осложненном течении могут возникать вторичные бактериальные инфекции – отиты, пневмонии. Тяжелые вторичные бронхопневмонии у детей 1 года жизни могут заканчиваться летально.Слайд 14
Иммунитет
После перенесенного заболевания или после вакцинации формируется
стойкий иммунитет, который поддерживается антителами и Т-лимфоцитами. Иногда возможна повторная инфекция, которая протекает в катаральной форме.Слайд 15Лабораторная диагностика
Клинический диагноз может быть установлен при выявлении типичных симптомов
заболевания.
Для лабораторной диагностики инфекции материалом для исследования является слизь задней
стенки носоглотки, взятая тампоном. Бактериологический метод эффективен в катаральный период болезни (более 90% позитивного культивирования). В конце периода пароксизмального кашля выделение возбудителей не превышает 10-20%.
Для прямого посева используют метод «кашлевых пластинок». Посев производят на среду Борде-Жангу или казеиново-угольный агар.
Слайд 16
Лечение
Основными препаратами для лечения коклюша являются антибиотики группы
макролидов/азалидов (эритромицин, азитромицин). Лечение в катаральной стадии болезни ускоряет элиминацию возбудителя, сокращает заразный период и может иметь профилактический эффект. Антибиотикотерапия в период пароксизмального кашля менее эффективна, возможно уменьшение тяжести и общей продолжительности заболевания.Слайд 17
Профилактика
Неспецифическая профилактика включает изоляцию и лечение больных. Осуществляют
введение препаратов иммуноглобулинов контактным лицам, организуют карантин на 14 дней для детей до 7 лет.Для специфической профилактики применяют АКДС (адсорбированную коклюшно-дифтерийную столбнячную вакцину) с трехмесячного возраста 3 раза с интервалом 45 дней с ревакцинацией в 18 месяцев. Для снижения реактогенности предпочтительным является использование ацеллюлярной (бесклеточной) коклюшной вакцины (АаКДС). В состав бесклеточной вакцины, могут входить коклюшный анатоксин, филаментозный гемагглютинин, мембранный протеин пертактин, антигены микроворсинок.